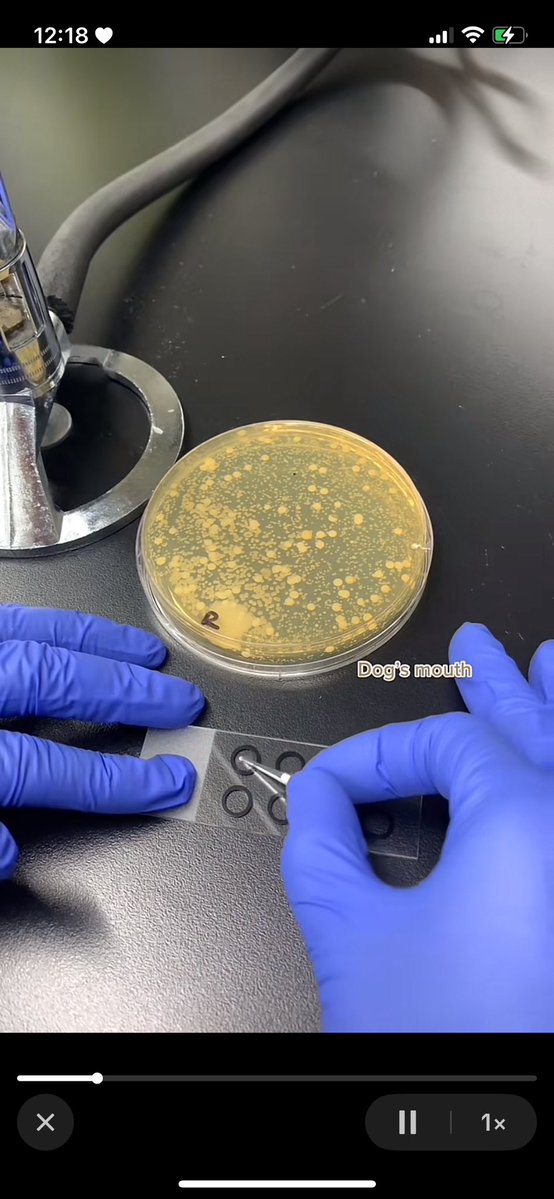
spiderspookie's tweet image. begging ppl to look up how much bacteria is in a dog’s tongue

me, my butch and our baby ⋆˚✿˖°

that never stopped them before
AND THE PLOT CONTINUES TO THICKEN After he alleged that the results of Miss Universe 2025 were rigged, Omar Harfouch escalated his allegations by publishing a photo that he claims shows Miss Universe owner Raul Rocha embracing Miss Mexico, Fatima Bosch, suggesting an “intimate”…

asked somebody with my dream physique to disclose his workout routine and he mentioned he only started working out a year ago let me just give up
your review center alone will not make you win miss universe
Guys, please take good care of your kidneys. Anlala sa dami nang taong dina dialysis ngayon. Mepa bata or matanda. Wala na kayong space sa mga dialysis center at mahal pa
begging ppl to look up how much bacteria is in a dog’s tongue
This is unironically cleaner than eating rice with your hands
That’s why accounting/audit matters!!! 2022 - EY 2023 - EY 2024 - BDO 2025 - Waley 🤯 #MissUniverse2025
finally may social media training na rin sila, wahhhh bumabalik na ulit trainings nila! go mnl48~ 🩵
Had a fun and productive day with @mnl48official for their social media training. Hope you learned something, girls! Always be rooting for your success. 🥹💖 See you! #MNL48


Not my usual post but this popular meme cat also known as meimei she is being abused by her owners constantly, please spread this around as the owner abuses them for likes and views. Justice for meimei
🚨URGENTE: has visto este gato? Ese mismo gato está siendo abusado por su propio dueño tole tole cat más conocida como meimei es una gata que se hizo viral por su expresión pero actualmente está siendo maltratada por el mismo dueño que la graba ella y entre otros gatos más

i can tell what kind of person you are by what you think of when you read “bp”
The K-ON! anime besides being mostly made by women, also actively cuts and censors fanservice from the source material. It also intentionally gives the characters more realistic and looser fitting clothes in their casual outfits. I thought these weird dudes hated that lol.


GUESS WHAT?! I turn Manato in a Marketable Sticker✨ Go get one while stock lasts!😆

IT'S SO HARD to govern when all your sitting senators, except one, are corrupt. This senate is an institutional failure.

Elves on the battlefields be like
United States トレンド
- 1. Caleb Love 2,717 posts
- 2. Mamdani 458K posts
- 3. Sengun 8,614 posts
- 4. Marjorie Taylor Greene 69.3K posts
- 5. Reed Sheppard 3,761 posts
- 6. Norvell 3,523 posts
- 7. Suns 19.9K posts
- 8. Collin Gillespie 3,887 posts
- 9. Lando 45.9K posts
- 10. Morgan Geekie N/A
- 11. #SmackDown 46.4K posts
- 12. UNLV 2,207 posts
- 13. Rockets 16.7K posts
- 14. Blazers 3,943 posts
- 15. Florida State 10.8K posts
- 16. Kerr 4,990 posts
- 17. Wolves 16.6K posts
- 18. #LasVegasGP 71.1K posts
- 19. The View 97.6K posts
- 20. Finch 2,803 posts
Something went wrong.
Something went wrong.


















































































































































